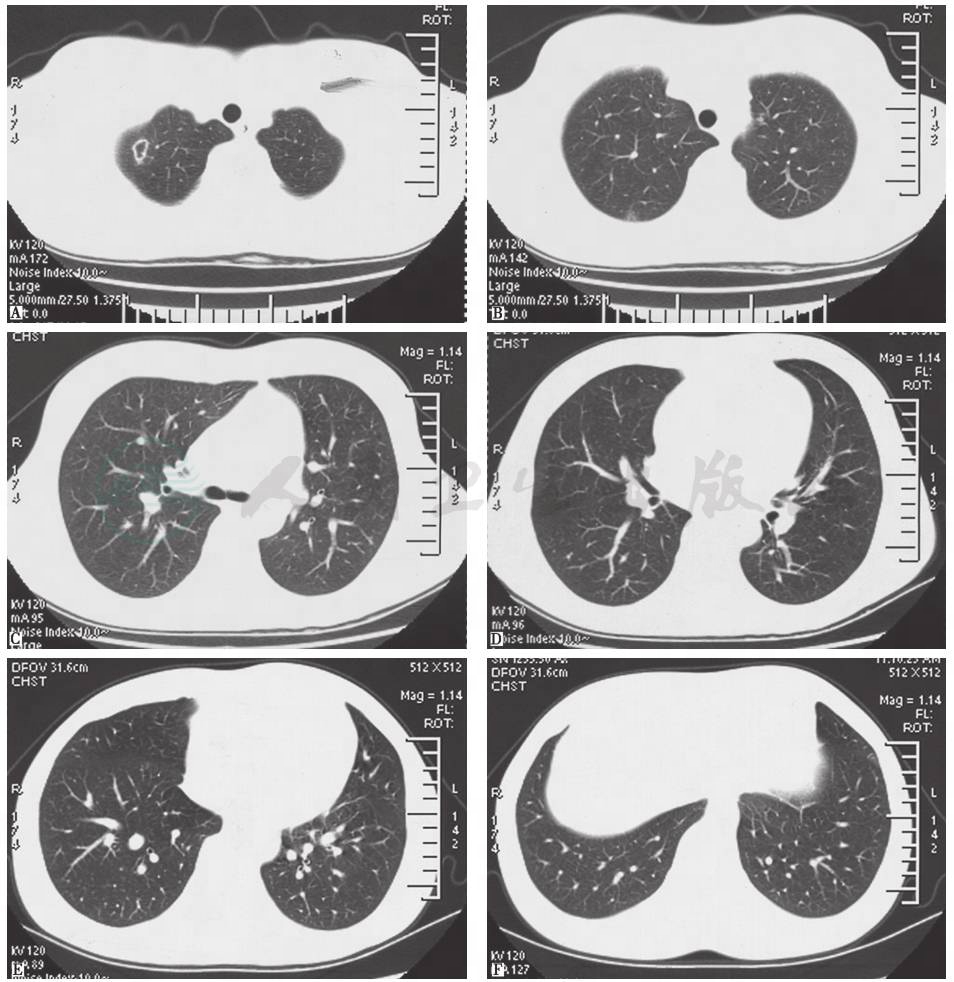
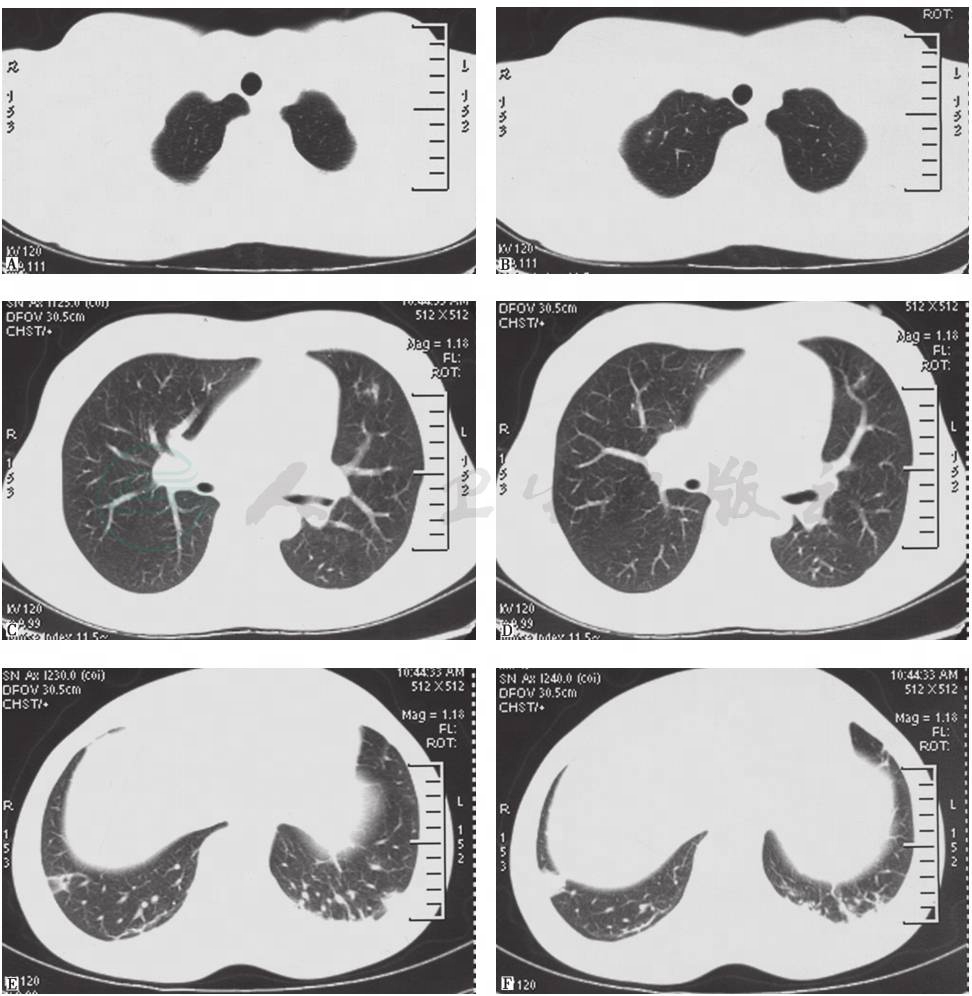

(一)病例信息
【病史】
女性患者,35岁,主因“间断发热5个月,阵发性胸痛伴咯血2个月余”于2015年3月16日收入院。5个多月前,患者受凉后出现寒战、发热(体温最高达39.8℃),伴头痛、流涕、大汗、乏力、肌肉酸痛,偶有咳嗽、咳白色黏痰,无喘憋、胸痛、盗汗,无腹痛、腹泻、关节疼痛,口服对乙酰氨基酚、清热解毒软胶囊,未见好转。胸部CT显示双肺散在小结节影。静脉滴注左氧氟沙星、头孢西丁、哌拉西林钠他唑巴坦钠(具体时间和先后顺序不详)后,患者症状好转。4个月前,患者再次出现发热(多于午后开始,体温最高为38℃),伴乏力、食欲缺乏,偶有咳嗽、咳白色黏痰,无寒战、盗汗、咯血症状。胸部CT显示除双肺散在小结节影外,还可见右上肺空洞。患者口服头孢类抗生素(具体不详)后,症状好转,但停药仍间断发热。2个半月前,患者出现胸骨后及左侧胸痛,呼吸时加重;胸部CT示双肺多发高密度影,伴膨胀不全、右侧胸腔积液和肺动脉增宽;超声心动图示先天性心脏病动脉导管未闭,肺动脉内径增宽,左心室扩大,二尖瓣轻-中度反流。临床按“肺炎、胸膜炎”,先后给予静脉滴注青霉素、盐酸莫西沙星和左氧氟沙星治疗,患者体温降为正常,胸痛一度缓解,但不久后胸痛再次加重,表现为胸骨后、左侧、右侧胸痛,呼吸时加重,身体取前倾屈曲位可缓解,且仍有间断发热(体温最高为38.5℃)。复查胸部CT示双肺散在斑片状高密度影减小,右肺下叶形成空洞影,胸腔积液完全吸收。患者住院进一步诊治。自发病以来,患者精神可,食欲可,大小便正常,体重无明显变化。
患者4个月前出现反复智齿疼痛合并一过性口腔溃疡;有先天性心脏病(动脉导管未闭),未治疗;有剖宫产手术史;无吸烟史,饮酒15年(相当于乙醇200g/d);其妹妹罹患白塞病。
【体格检查】
体温38℃,呼吸22次/分,血压110/60mmHg,心率88次/分。全身皮肤、黏膜无黄染、出血点和皮疹。左侧腋窝可触及单个黄豆大小淋巴结,质韧,无触痛,无粘连,其余浅表淋巴结无肿大。扁桃体无肿大。双肺呼吸音清,未闻干、湿啰音。心界向左扩大,心律齐,胸骨左缘第2肋间可闻4/6级连续性双期杂音,局部可触及震颤,其余瓣膜听诊区未闻病理性杂音。腹部查体未见异常。双下肢无水肿。
【实验室检查】
发病以来血常规及血沉检查结果见表1。
表1 血常规及血沉检查结果

WBC:白细胞;N:中性粒细胞;L:淋巴细胞;Hb:血红蛋白;PLT:血小板;ESR:血沉
日期 WBC(109/L) N(%) L(%) Hb(g/L) PLT(109/L) ESR(mm/1h) |
2014年10月14日 5.50 79.5 13.8 113 147 - 2014年12月17日 5.96 62.1 29.5 112 253 42 2015年1月6日 7.85 71.8 18.9 107 257 86 2015年1月23日 6.45 69.7 22.9 105 216 25 2015年3月5日 8.66 65.3 27.6 116 266 - 2015年3月13日 - - - - - 32 2015年3月16日(入院) 8.21 80.5 13.4 110 251 - |
引自:主编:.呼吸系统疑难病例诊疗辨析.第1版.ISBN:978-7-117-26415-0
CRP 35.29mg/L(2014年12月17日)。
结核抗体阳性(2015年1月6日),痰抗酸杆菌涂片未发现抗酸杆菌(2014年12月31日),T-SPOT阴性(2015年3月13日)。
【影像学检查】
胸部CT(2014年10月16日):双肺散在小结节影,未见结节空洞改变、肺门和纵隔淋巴结肿大和胸腔积液征象(图1)。
胸部CT(2014年12月23日):双肺散在结节影,边界模糊,右肺上叶见薄壁空洞影,未见肺门和纵隔淋巴结肿大,未见双侧胸膜积液(图2)。


图1 胸部CT表现(2014-10-16)
图2 胸部CT表现(2014-12-23)
引自:主编:.呼吸系统疑难病例诊疗辨析.第1版.ISBN:978-7-117-26415-0
胸部CT(2015年1月6日):双肺多发高密度影,右下肺明显,双侧少量胸腔积液,肺动脉增宽,纵隔未见肿大淋巴结影(图3)。

图3 胸部CT表现(2015-01-06)
引自:主编:.呼吸系统疑难病例诊疗辨析.第1版.ISBN:978-7-117-26415-0
胸部CT(2015年1月23日):双肺内散在斑片状高密度影较前有所吸收,右肺下叶斑片影可见小空洞形成,双侧胸腔积液吸收、好转(图4)。
胸部CT(2015年3月1日):仅见右肺小结节影、索条影,右下肺近肋膈角处高密度楔形影,未见胸腔积液(图5)。
超声心动图(2015年1月8日):射血分数(EF)56.1%,先天性心脏病动脉导管未闭,肺动脉内径增宽,左心室扩大,二尖瓣轻中度反流。
图4 胸部CT表现(2015-01-23)
引自:主编:.呼吸系统疑难病例诊疗辨析.第1版.ISBN:978-7-117-26415-0


图5 胸部CT表现(2015-03-01)
(二)临床思辨
【临床特点】
1.患者为青年女性,急性起病,反复发作。
2.主要症状和体征为反复发热、间断少量咯血、胸痛。
3.患者有肺动脉导管未闭病史,未治疗;一妹妹罹患白塞病。
4.实验室检查显示外周血白细胞正常、血沉增快,CRP增高。
5.影像学检查显示肺部斑片状渗出影、实变、囊性空洞形成,病灶变化快。
6.反复多轮抗细菌治疗初期可减轻或缓解症状,但作用不能持续。
【思辨要点】
本例患者患有肺动脉导管未闭,5个月来反复发热、咯血、胸痛,肺部出现动态变化的多灶性、多形性病变(有磨玻璃影、实变、空洞等形态)。针对这些特点,在确立诊断过程中需要思考以下问题:
1.哪些疾病可能出现反复发热、咯血、胸痛,伴肺内多部位、多形态伴空洞性病变?
(1)感染性疾病
例如,肺内支气管播散或血行播散性感染、感染性心内膜炎、脓毒性栓塞等,均可引起反复发热、咯血、胸痛,胸部CT可见肺内多灶、多形性病变。致病菌包括细菌、真菌、结核分枝杆菌等。本病例病程中,患者反复应用抗感染治疗,初期均有短暂好转,体温恢复正常、症状减轻,说明头孢、左氧氟沙星类药物有作用,因此考虑为感染性疾病可能性大。此外,患者患有先天性动脉导管未闭,故尤其应警惕感染性心内膜炎。
(2)自身免疫性疾病
血管炎、系统性红斑狼疮、白塞病等疾病进展累及肺部时,患者可出现发热、咯血等症状,肺内可出现多灶、多形态病灶。其中,白塞病是一种可累及全身的血管炎性疾病,最常见的表现为反复口腔溃疡、生殖器溃疡和虹膜炎,肺部表现包括肺动脉瘤、肺动脉栓塞、肺部结节(图6)、磨玻璃影、胸膜肥厚、胸腔积液、淋巴结增大、肺气肿或肺大疱。本例患者有白塞病家族史,故应警惕该病。

图6 白塞病胸部影像学表现
男性患者,32岁,主因发热、咳嗽、咯血、体重下降2个月入院;反复出现口腔溃疡、生殖器溃疡、下肢结节性红斑,皮肤针刺试验阳性;肺部实变活检提示出血、机化性血栓、血管增生。胸部X线片可见双肺多发斑片影伴左侧胸腔积液(A);胸部CT提示双肺多发结节、实变,左侧胸腔积液(B)。诊断为白塞病
引自:主编:.呼吸系统疑难病例诊疗辨析.第1版.ISBN:978-7-117-26415-0
(3)肿瘤性疾病
患者可出现咯血、胸痛、发热等症状,肺部影像学表现可有磨玻璃影、实变影、空洞性病变等,随时间延长而进展。本病例经抗感染治疗后,病灶有所缩小、吸收,故考虑为肺部肿瘤性病变的可能性小。
2.如果本病例为感染性疾病所致,病变部位在何处?致病病原体是什么?如何明确诊断?
本例患者有肺动脉导管未闭基础疾病,目前无左心系统远端受累表现,但肺内呈现多发病变,故考虑为右心系统受累的感染性心内膜炎可能性大。根据感染性心内膜炎改良DUKE诊断标准,经胸、食管超声心动及肺动脉增强CT可协助明确感染性栓子来源。对先天性心脏病患者而言,较多见右心感染性心内膜炎,感染病原常为葡萄球菌及链球菌。
对于本病例,可在患者病情稳定的前提下,停用抗生素,取血培养,以协助明确病原学诊断。
血培养结果有助于明确菌血症、感染性心内膜炎的诊断。血培养采样原则:局部充分消毒,双部位或三部位采血,每个部位分别抽取20ml,于床旁直接接种(需氧菌培养瓶8~10ml、厌氧菌培养瓶8~10ml、结核真菌培养瓶2~5ml)。
(一)临床信息
【实验室检查】
病原检测:肺炎衣原体抗体阴性,肺炎支原体抗体阳性(1∶40),嗜肺军团菌IgG及IgM抗体阴性。HBV、HCV、HIV、梅毒螺旋体抗体检测均阴性。取左上肢及右上肢血,做血培养24~48小时,均见革兰阳性球菌——粪肠球菌,且对氨苄西林、左氧氟沙星、青霉素G、替考拉宁、万古霉素均敏感。
免疫相关检查:免疫球蛋白G 18.8g/L,自身抗体(ANA、ANCA、ENA)未见异常。
【影像学等辅助检查】
心电图(2015年3月17日):窦性心律,心电轴不偏,ST-T段无异常。
腹部彩超(2015年3月17日):未见异常。
妇科彩超(2015年3月17日):子宫腔有少量积液。
双下肢静脉彩超(2015年3月17日):双下肢深、浅静脉血流通畅。
经食管超声心动图(2015年3月19日):心脏各瓣膜未见明显赘生物。
【气管镜检查】
支气管镜下表现:可见部分支气管黏膜下毛细血管扩张,未见其他异常(图7)。
支气管肺泡灌洗液(右中肺内侧段):细胞总数0.31×106/ml;其中,巨噬细胞72%,淋巴细胞23%,分叶核细胞5%,嗜酸性粒细胞0%,嗜碱性粒细胞0%;普通细菌涂片偶见革兰阴性菌;真菌涂片未找到真菌菌丝;浓缩抗酸杆菌阴性。
【眼科会诊】
未见眼底异常。

A.气管隆嵴;B.左主支气管;C.左上叶支气管;D.左下叶支气管;E.右上叶支气管;F.右中间段支气管;

G.右中叶支气管;H.右下叶支气管
图7 气管镜检查镜下表现
(二)临床思辨
患者入院后的系列检查显示:①一次血培养(多部位6管血标本)均培养出粪肠球菌;②两次超声心动检查(包括经食管超声)均未见赘生物;③支气管镜下表现基本正常,未见气道感染表现;④无反复口腔、生殖器溃疡以及皮肤、眼等症状,免疫学检查阴性,皮肤针刺反应阴性。
1.本病例,目前是否可以明确病原菌为粪肠球菌?来源于何处?
本病例多部位取样血培养结果一致,均见粪肠球菌,因此考虑菌血症诊断明确,肺部病灶明确为粪肠球菌感染。粪肠球菌是口腔常见定植菌,本例患者曾有反复智齿疼痛及一过性口腔溃疡病史,而无腹痛、腹泻、肛周破溃等病史,故考虑粪肠球菌来源于口腔牙源性感染的可能性。
2.本病例是否合并感染性心内膜炎?
对于本病例,牙源性感染不能解释无口腔症状时的反复发热及病情迁延,因此还应考虑有合并感染性心内膜炎的可能性。对常规超声检查未显示明确赘生物者,如果存在肺动脉导管未闭基础病,则应关注右心系统是否存在异常,尤其应密切观察动脉导管肺动脉开口血流易形成湍流的部位,可行肺动脉增强CT、肺动脉超声仔细甄别。
(一)临床信息
肺动脉增强CT(2015年3月20日):肺动脉宽3.5cm,肺动脉主干左侧内壁略毛糙,可见点状充盈缺损区(图8)。与2015年1月6日胸部CT相比,左肺下叶有新出现的多发病灶,原多发感染病灶大部分有所吸收,原右侧胸腔积液吸收(图9)。
超声心动图(2015年3月24日):根据影像学检查提供的信息,再次行超声心动检查,发现动脉导管开口对侧肺动脉壁有黄豆大小赘生物,随血流漂动(图10)。

图8 肺动脉增强CT表现(2015-03-20)
引自:主编:.呼吸系统疑难病例诊疗辨析.第1版.ISBN:978-7-117-26415-0


图9 胸部CT表现(2015-03-20)

图10 超声心动图
引自:主编:.呼吸系统疑难病例诊疗辨析.第1版.ISBN:978-7-117-26415-0
腹部CT(2015年3月25日):肝S4段见低密度灶,肠系膜上见少许小淋巴结,右肾小血管平滑肌脂肪瘤可能。
最后诊断:①脓毒性肺栓塞;②肺动脉导管未闭;③感染性肺动脉内膜炎。
根据药敏试验结果,采取规律青霉素G联合左氧氟沙星抗感染治疗后,患者体温恢复正常,未再发热、咯血。
(二)临床思辨
本病例诊疗过程中,从肺动脉导管未闭基础疾病出发,结合反复发热、胸痛、咯血的临床表现,考虑到右心肺动脉内膜炎可能,并通过停药、取血培养找到粪肠球菌的确切证据,同时有针对性地寻找动脉导管未闭病理生理改变可能累及的部位(如肺动脉和右心室等),从而明确了感染性肺动脉内膜炎的诊断。由于反复肺动脉菌栓栓塞导致肺内感染,虽曾进行多次抗感染治疗,但疗程不足,为治疗效果不佳的原因。
如何选择最佳治疗方案是此时关键所在。
1.对于感染性心内膜炎,应如何选用抗生素?
根据2014年《成人感染性心内膜炎预防、诊断、治疗专家共识》,粪肠球菌对氨苄西林和青霉素敏感。对敏感肠球菌可采取静脉滴注阿莫西林(2g,每4小时1次)4~6周,或静脉滴注青霉素(2.4g,每4小时1次)联合庆大霉素(1mg/kg,每12小时1次4~6周,或阿莫西林(2g,每4小时1次)至少6周。
2.肺动脉导管未闭患者发生细菌性心内膜炎时,应如何选择手术时机?
一般来讲,对于肺动脉导管未闭患者,在发生细菌性心内膜炎时,应暂缓手术,可先给予抗感染治疗,待感染控制后2~3个月再进行手术。
本病例最终确诊为肺动脉导管未闭、感染性肺动脉内膜炎合并脓毒性肺栓塞,患者反复发热、并发胸痛、咯血,肺内影像学表现呈现多部位、多形态特点。本例患者在病程中反复进行抗感染治疗,均短期有效,但病情迁延,与给药频度及疗程不足相关。在诊疗过程中,多次超声心动检查未发现赘生物,最终依靠临床思维的指引,予以停用抗生素后规范取血培养,并完善肺动脉增强CT以及仔细进行肺动脉超声检查得以明确赘生物部位、完善诊断。可见,建立合理的临床思路,对正确诊断至关重要。
(暴婧 高占成)
1.Bilgin G,Sungur G,Kucukterzi V.Systemic and pulmonary screening of patients with Behçet's disease during periodic follow-up.Respiratory Medicine,2013,107(3):466-471.
2.Seyahi E,Melikoglu M,Akman C,et al.Pulmonary artery involvement and associated lung disease in Behçet disease :a series of 47 patients.Medicine,2012,91(1):35-48.
3.Malekmohammad M,Emamifar A.Pulmonary Nodules as an Initial Manifestation of Behçet’s Disease.Case Reports in Rheumatology,2014,2014:869817.
4.Bathoorn E,Heitbrink MA,Reichert CL,et al.A turbulent cause of bilateral pneumonia.European Respiratory Journal,2009,33(6):1513-1516.
5.中华医学会心血管病学分会.成人感染性心内膜炎预防、诊断和治疗专家共识.中华心血管病杂志,2014,42(10):806-816.
6.Sugimura Y,Katoh M,Toyama M.Patent ductus arteriosus with pulmonary endarteritis.Internal Medicine,2013,52(18):2157-2158.













